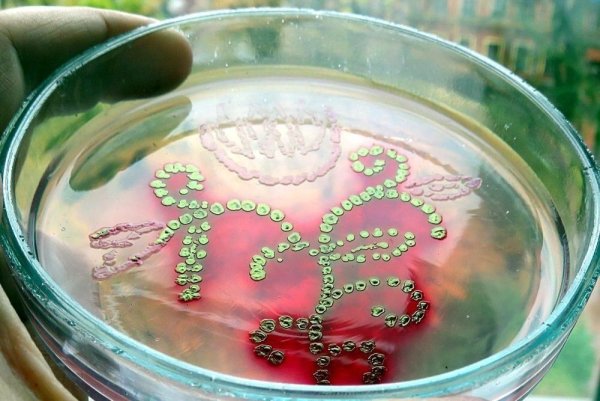
Чашка Петри рисунок
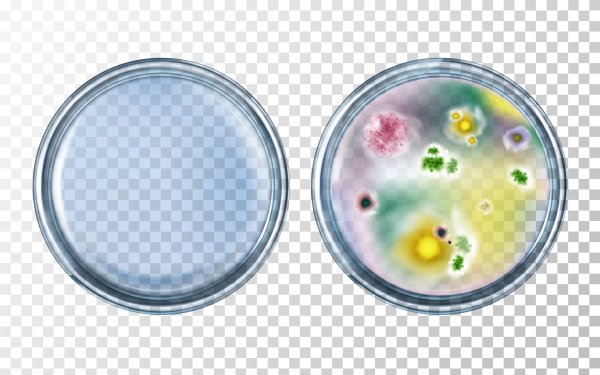
Чашка Петри иконка

Рисунок чашка Петри - это графическое изображение лабораторной посуды, которая используется для выращивания микроорганизмов и клеток. Чашка Петри представляет собой плоскую круглую посудину с прозрачным крышкой, которая позволяет наблюдать за процессами роста и развития бактерий, грибов или клеток. На рисунке можно увидеть детали конструкции чашки Петри, такие как выпуклое дно, гладкие стенки и эргономичную форму, обеспечивающую удобство работы в лаборатории. Этот рисунок может быть полезным для биологов, медиков, исследователей и студентов, которые изучают микробиологию и клеточную биологию.
Белая чашка Петри
Чашка Петри рисунок
Пустая чашка Петри
Чашка Петри чертеж
Чашка Петри
Чашка Петри схема
Чашка Петри раскраска
Чашка Петри схема
Чашка Петри химическая
Чашки Петри с бактериями иллюстрации
Чашка Петри схема
Чашка Петри иконка
Чашка Петри рисунок
Чашка Петри рисунок
Чашка Петри Фло
Чашка Петри рисунок
Чашка Петри на белом фоне
Чашка Петри вектор
Чашка Петри вектор
Чашка Петри рисунок
Чашка Петри рисунок
Чашка Петри иконка
Чашка Петри вектор
Чашка Петри схема
Чашка Петри рисунок
Чашка Петри нарисовать
Чашка Петри рисунок
Чашка Петри рисунок без фона
Чашка Петри на прозрачном фоне
Микробиология бактерии в чашке Петри
Чашка Петри рисунок
Чашка Петри на прозрачном фоне
Чашка Петри иконка
Чашка Петри с бактериями на белом фоне
Чашка Петри на белом фоне
Картины бактериями в чашке Петри
Агар агар в чашке Петри
Чашка Петри микробиология
Агар агар в чашке Петри
Микробиолог чашка Петри
Рисунок чашка Петри биология
Чашка Петри вектор
Чашка Петри лого
Микроорганизмы эмблема
Чашка Петри вектор
Смотрите онлайн или можете скачать на телефон или компьютер в хорошем качестве совешенно бесплатно. Не забывайте оставить комментарий и посмотреть другие фотографии и изображения высокого качества, например рисунок архитектурное сооружение и фиксики рисунок из раздела Рисунки

Grizly.club
Grizly.club